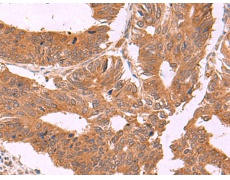
一抗

中文名稱:兔抗ZBTB33多克隆抗體
|
Background: |
This gene encodes a transcriptional regulator with bimodal DNA-binding specificity, which binds to methylated CGCG and also to the non-methylated consensus KAISO-binding site TCCTGCNA. The protein contains an N-terminal POZ/BTB domain and 3 C-terminal zinc finger motifs. It recruits the N-CoR repressor complex to promote histone deacetylation and the formation of repressive chromatin structures in target gene promoters. It may contribute to the repression of target genes of the Wnt signaling pathway, and may also activate transcription of a subset of target genes by the recruitment of catenin delta-2 (CTNND2). Its interaction with catenin delta-1 (CTNND1) inhibits binding to both methylated and non-methylated DNA. It also interacts directly with the nuclear import receptor Importin-α2 (also known as karyopherin alpha2 or RAG cohort 1), which may mediate nuclear import of this protein. Alternatively spliced transcript variants encoding the same protein have been identified. |
|
Applications: |
ELISA, IHC |
|
Name of antibody: |
ZBTB33 |
|
Immunogen: |
Synthetic peptide of human ZBTB33 |
|
Full name: |
zinc finger and BTB domain containing 33 |
|
Synonyms: |
ZNF348; ZNF-kaiso |
|
SwissProt: |
Q86T24 |
|
ELISA Recommended dilution: |
5000-10000 |
|
IHC positive control: |
Human colorectal cancer and Human cervical cancer |
|
IHC Recommend dilution: |
40-200 |


 購物車
購物車 幫助
幫助
 021-54845833/15800441009
021-54845833/15800441009